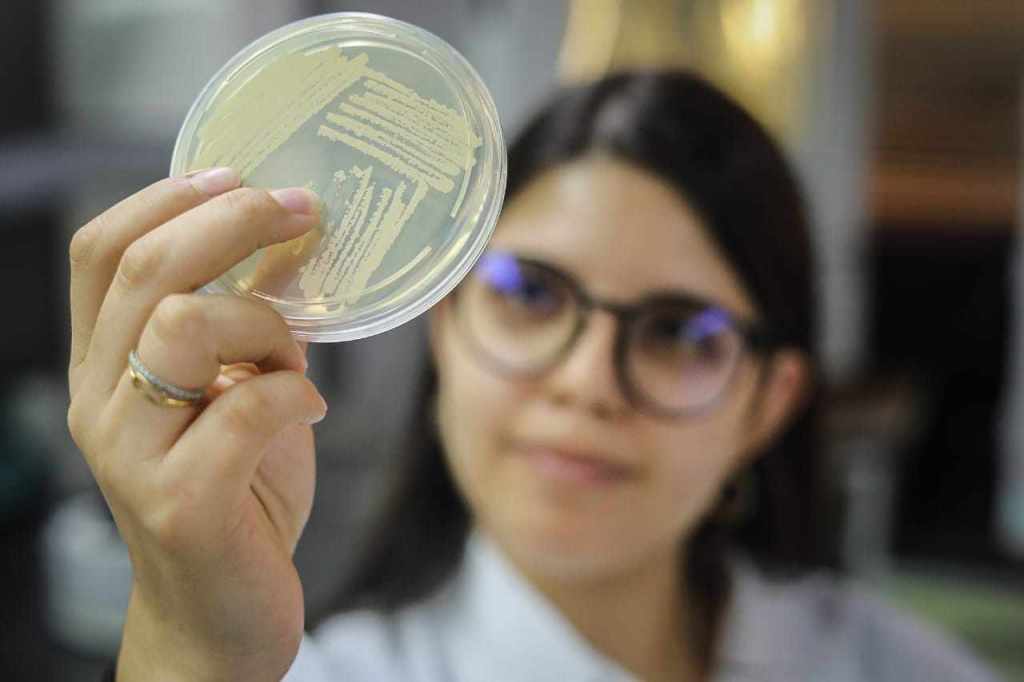

Un grupo de 12 científicos venezolanos de la Fundación Instituto de Estudios Avanzados (IDEA), ente adscrito al Ministerio del Poder Popular para Ciencia y Tecnología (Mincyt), crearon Bioeya, un biosurfactante dirigido al saneamiento de ecosistemas acuáticos y terrestres del país.
La línea de investigación responde a la necesidad de disponer en Venezuela, de un producto que remueva los hidrocarburos en suelos y agua en caso de derrames petroleros, y que responda a lo establecido en el Plan de la Patria 2019-2025, en su Gran Objetivo Histórico N° 5, que exhorta a contribuir a la preservación de la vida en el planeta y la salvación de la especie humana.
El desarrollo de este producto también se vincula con el cumplimiento de la Agenda 2030 y los Objetivos de Desarrollo Sostenible de la Organización de Naciones Unidas (ONU).
Bioeya es un biosurfactante biodegradable de baja toxicidad y por su composición es agradable con el ambiente. Venezuela por ser un país petrolero, no escapa de tener sitios afectados con hidrocarburos; este producto viene a ser apoyo en el saneamiento de los ecosistemas acuáticos y terrestres, explicó la investigadora de la Dirección de Energía y Ambiente del IDEA, Laynet Puentes.

Bajo el lema: Hacer ciencia para la vida, los investigadores iniciaron la búsqueda de un surfactante que se diferenciara de otros y protegiera realmente al ambiente. Con ese fundamento nació el proyecto financiado por el Fondo Nacional de Ciencia, Tecnología e Innovación (Fonacit).
El origen de Bioeya es biológico, proviene de otros microorganismos cómo hongos, bacterias o levaduras, esto le permite reducir la toxicidad en los ecosistemas donde es agregado, logrando dispersar los hidrocarburos en los cuerpos de agua y reduciendo el efecto de los contaminantes.
Además disminuye costos a la nación, dado que su aplicación requiere menos dosis, a diferencia de los surfactantes químicos.

¿Qué es y qué hace un biosurfactante?
La licenciada en Química y doctorante en Ciencias de la Ingeniería, Francys Gómez, expuso que un surfactante es una sustancia de origen biológica o química capaz de incidir en la superficie de contacto entre dos fases, por ejemplo, el agua y el aceite o el agua y el aire. En ese sentido, por ser de origen biológico se denominan biosurfactantes.
Bioeya es un nombre compuesto: Bio, de la palabra Biológico y Eya, que son las iniciales de la Dirección de Energía y Ambiente del IDEA, comentó la integrante del proyecto la licenciada en Biología Celular y estudiante de Biotecnología con aplicación a la Energía y Ambiente, Ángela De Sisto.

Este biosurfactante tiene varias aplicaciones, una de ellas, en la industria farmacéutica cosmética donde puede ser utilizado para fabricar cremas para el cuidado de la piel, también en el área agrícola donde puede inhibir patógenos que causan diversas enfermedades en cultivos, y en el saneamiento ambiental, precisó.
Fases de producción de Bioeya
Para hacer los biosurfactantes los investigadores se trasladan al Laboratorio de Microbiología, donde identifican las cepas capaces de producir surfactantes.
Esto se logra mediante la incubación de los microorganismos en medios de cultivos ricos, y una vez cultivados pasan al centrifugado donde se elige el excreto de las bacterias o biosurfactante.

Luego, estos biosurfactantes obtenidos de la centrifugación, pasan por un proceso de filtración en el cual se quita parte del medio de cultivo que no interesa para quedarse con el producto final.
Después, en el Laboratorio de Biología Molecular, estas cepas son identificadas genéticamente para poder comprobar qué tipos de surfactantes están produciendo.
Finalmente, en el Laboratorio de Físico-Química se hace la caracterización del biosurfactante, mediante un sistema infrarrojo y con un tensiómetro para cuantificar la cantidad de surfactante que las bacterias han producido.
¿Cómo se usa Bioeya?
Para la aplicación de este producto es necesario tener en cuenta el tipo de suelo o de agua a tratar, así como sus contaminantes que pueden ser: gasoil, gasolina, crudo liviano, pesado o extrapesado.
En el sitio web Masciencia.com.ve precisan que, para la aplicación en suelo al uno por ciento, se agregan 10 mililitros (ml) de Bioeya en 1 litro de agua, y se administra en un metro cúbico de suelo afectado (1 m³) lo que puede ser aplicado con atomizador.

Para la aplicación en agua al 10 por ciento, los creadores de Bioeya recomiendan agregar 10 ml del biosurfactante en 100 ml de agua, y se coloca en 1 m³ de agua afectada a través de un spray. El biosurfactante viene en tres presentaciones de 1 litro, 20 litros, 150 litros y 40.000 litros.
Actualmente, Bioeya, es un producto pionero que se encuentra en el Parque Científico Tecnológico de Venezuela + Ciencia, ubicado en el Instituto Venezolano de Investigaciones Científicas (IVIC), en los Altos Mirandinos, desde donde se hace el escalamiento del biosurfactante con proyección hacia su producción industrial.
